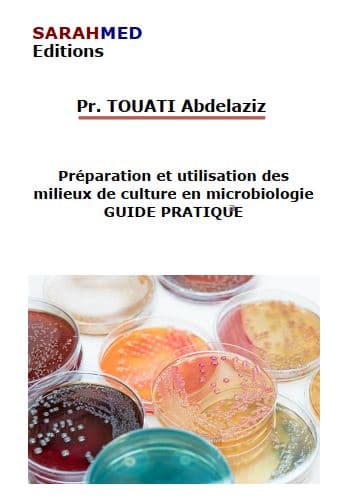
Couverture — Préparation et utilisation des milieux de culture en microbiologie : Guide pratique

Publication vérifiée — éditée officiellement par SARAHMED Éditions
Préparation et utilisation des milieux de culture en microbiologie : Guide pratique
Abdelaziz TOUATI
- Pages
- 398
- Type
- Livre
Résumé
Le livre "Préparation et utilisation des milieux de culture en microbiologie : guide pratique" offre une présentation claire et concise de la composition, de la préparation et de l'utilisation des milieux de culture en microbiologie. Il s'adresse aux étudiants et aux professionnels du domaine et fournit des instructions détaillées sur les différentes étapes de la préparation des milieux de culture, ainsi que des exemples pratiques pour leur utilisation efficace.